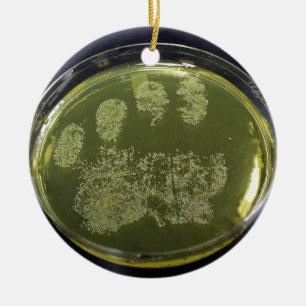

Popular Bacteria Christmas Tree Decorations
45 results
Microbe ornament
Price$34.05
Bacteria Ceramic Tree Decoration
Price$36.15
Colourful bacteria ceramic tree decoration
Price$36.15
Going to work in 2021 metal tree decoration
Price$50.95
Love a Microbiologist Metal Tree Decoration
Price$51.55
E-coli Cells 2 Metal Tree Decoration
Price$48.65
Bacteria Ceramic Tree Decoration
Price$36.15
Microscopic Microbes Ceramic Tree Decoration
Price$36.15
SUPPORT BACTERIA CERAMIC TREE DECORATION
Price$35.95
Blue Delft Biohazard Ceramic Tree Decoration
Price$34.05
virus ceramic tree decoration
Price$32.15
Bacteria Ceramic Tree Decoration
Price$34.05
Penumonia Bacteria Metal Tree Decoration
Price$49.20
Bacteriophage Ceramic Tree Decoration
Price$33.65
Biology Science Ceramic Tree Decoration
Price$34.00
Bacteria Ceramic Tree Decoration
Price$36.15
Still can't find what you're looking for?
Search Feedback
If you need help or have a question for Customer Service, please visit our Help Centre
Recently Viewed Items